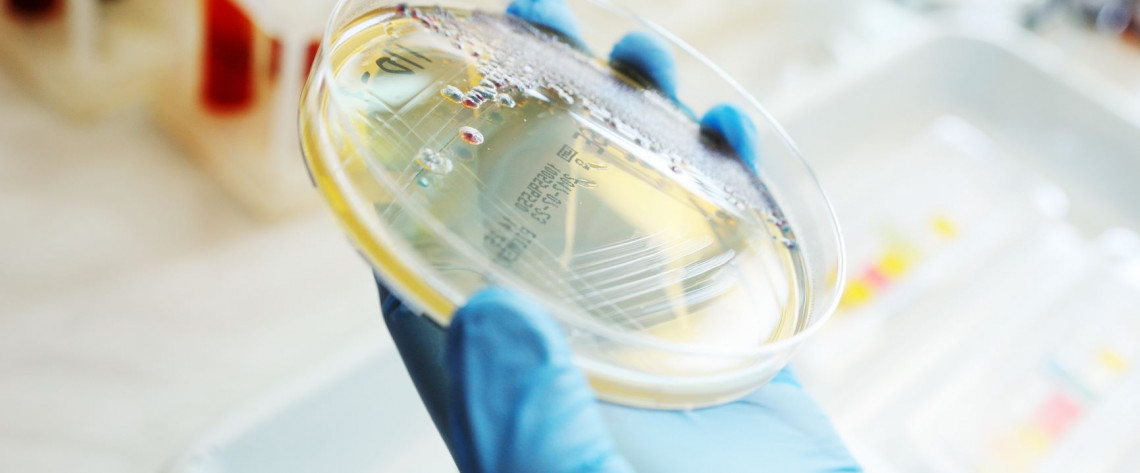

Copper Surfaces Provide Continuous Protection Against SARS-CoV-2
The U.S. EPA granted an unprecedented public health registration permitting certain copper alloys to be marketed and sold with long-lasting efficacy claims against SARS-CoV-2, Rhinovirus and other viruses. Copper alloys are the first and only products to be included on EPA's List N Appendix of products with residual virucidal efficacy.